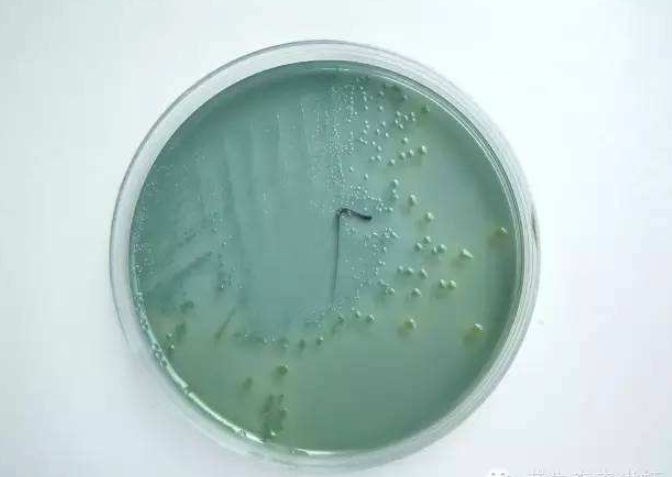
虫见愁南美白对虾红体黄鳃白便偷死是弧菌又开始猖獗了
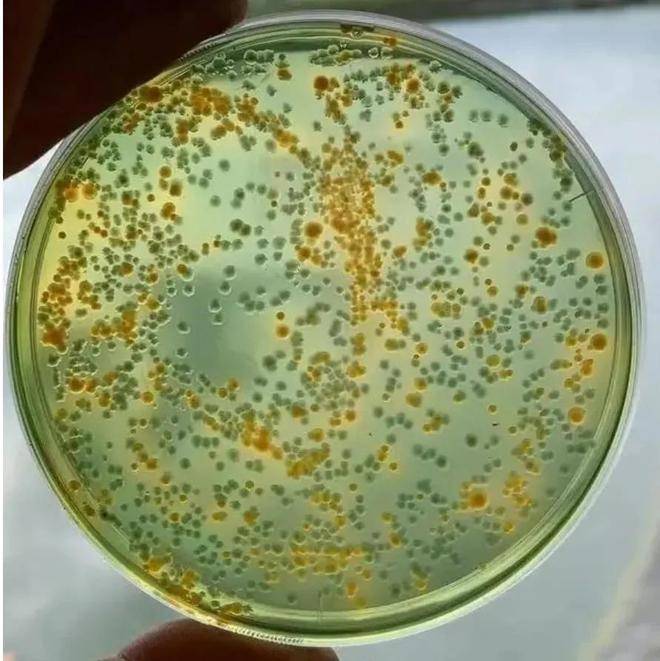
成都丰昱水产养殖有限公司-对虾偷死,红体,原来都是弧菌惹的祸!

黄弧菌图片

弧菌超标的处理
图片尺寸858x511
南美白对虾养殖过程中弧菌的那些事儿
图片尺寸660x700
外塘对虾放苗窗口期,莫要让弧菌,肝肠孢虫肆虐
图片尺寸1280x748
虫见愁南美白对虾红体黄鳃白便偷死是弧菌又开始猖獗了
图片尺寸672x477
夏天高温肠炎白便爆发,把弧菌赶尽杀绝才安心
图片尺寸640x853
视频教学弧菌检测及灭弧实验
图片尺寸478x512
黄弧菌:溶藻弧菌,霍乱弧菌,哈维氏弧菌,鳗弧菌.
图片尺寸660x800
弧菌弧菌属
图片尺寸1200x798
某苗场的玻璃苗检测黄弧菌超标
图片尺寸1080x1119
想知道怎么预防和治疗池塘里的弧菌吗?
图片尺寸1002x461
具有不透明中心和半透明的边缘菌属:革兰氏阴性菌又名:黄弧菌中文名
图片尺寸627x425
海洋创伤弧菌是什么_海洋创伤弧菌简介_谋历史网
图片尺寸500x283
图2 拟态弧菌在tsa培养基上的菌落形态拟态弧菌为革兰氏阴性菌,具有单
图片尺寸1080x864
这几个要点,帮你轻松处理弧菌_养殖_对虾_繁殖
图片尺寸800x528
苗场检测苗体弧菌含量时,弧菌(黄弧菌)含量,小苗不超过30cfu/尾,副
图片尺寸378x473
技术| 五六月份,弧菌开始在对虾塘活动了,这份弧菌防控方案请拿好!
图片尺寸409x520
成都丰昱水产养殖有限公司-对虾偷死,红体,原来都是弧菌惹的祸!
图片尺寸660x661
颗粒等,引发池塘溶氧不足,造成虾塘水质底质恶化,利于弧菌的生长繁殖
图片尺寸998x746
弧菌弧菌属
图片尺寸350x274
想要提高对虾放苗初期的成活率,这四个重点,你知道吗?
图片尺寸500x250



















.jpg)